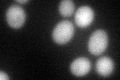
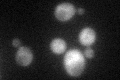

View description
Porphobilinogen deaminase, catalyzes the conversion of 4-porphobilinogen to hydroxymethylbilane, the third step in heme biosynthesis; localizes to the cytoplasm and nucleus; expression is regulated by Hap2p-Hap3p, but not by levels of heme
Localization:
Intensity:
Fold change:
Significance:
-
C’ GFP library in SD

cytosol60.63 -
N' NOP1pr-GFP in SD

cytosol122.068 -
N' TEF2pr-mCherry in SD

cytosol127.147 -
N' NATIVEpr-GFP in SD

cytosol33.9879 -
N' TEF2pr-VC and Cyto-VN in SD

#N/A0 -
C’ GFP library in SD+DTT
cytosol46.640.76No -
C’ GFP library in SD+H2O2
cytosol65.571.08No -
C’ GFP library in Starvation Media

cytosol38.230.63No -
C’ GFP library on the background of Pup2-DaMP

cytosol -
C’ GFP library on the background of CCT mutant

cytosol63.53621.04776No
